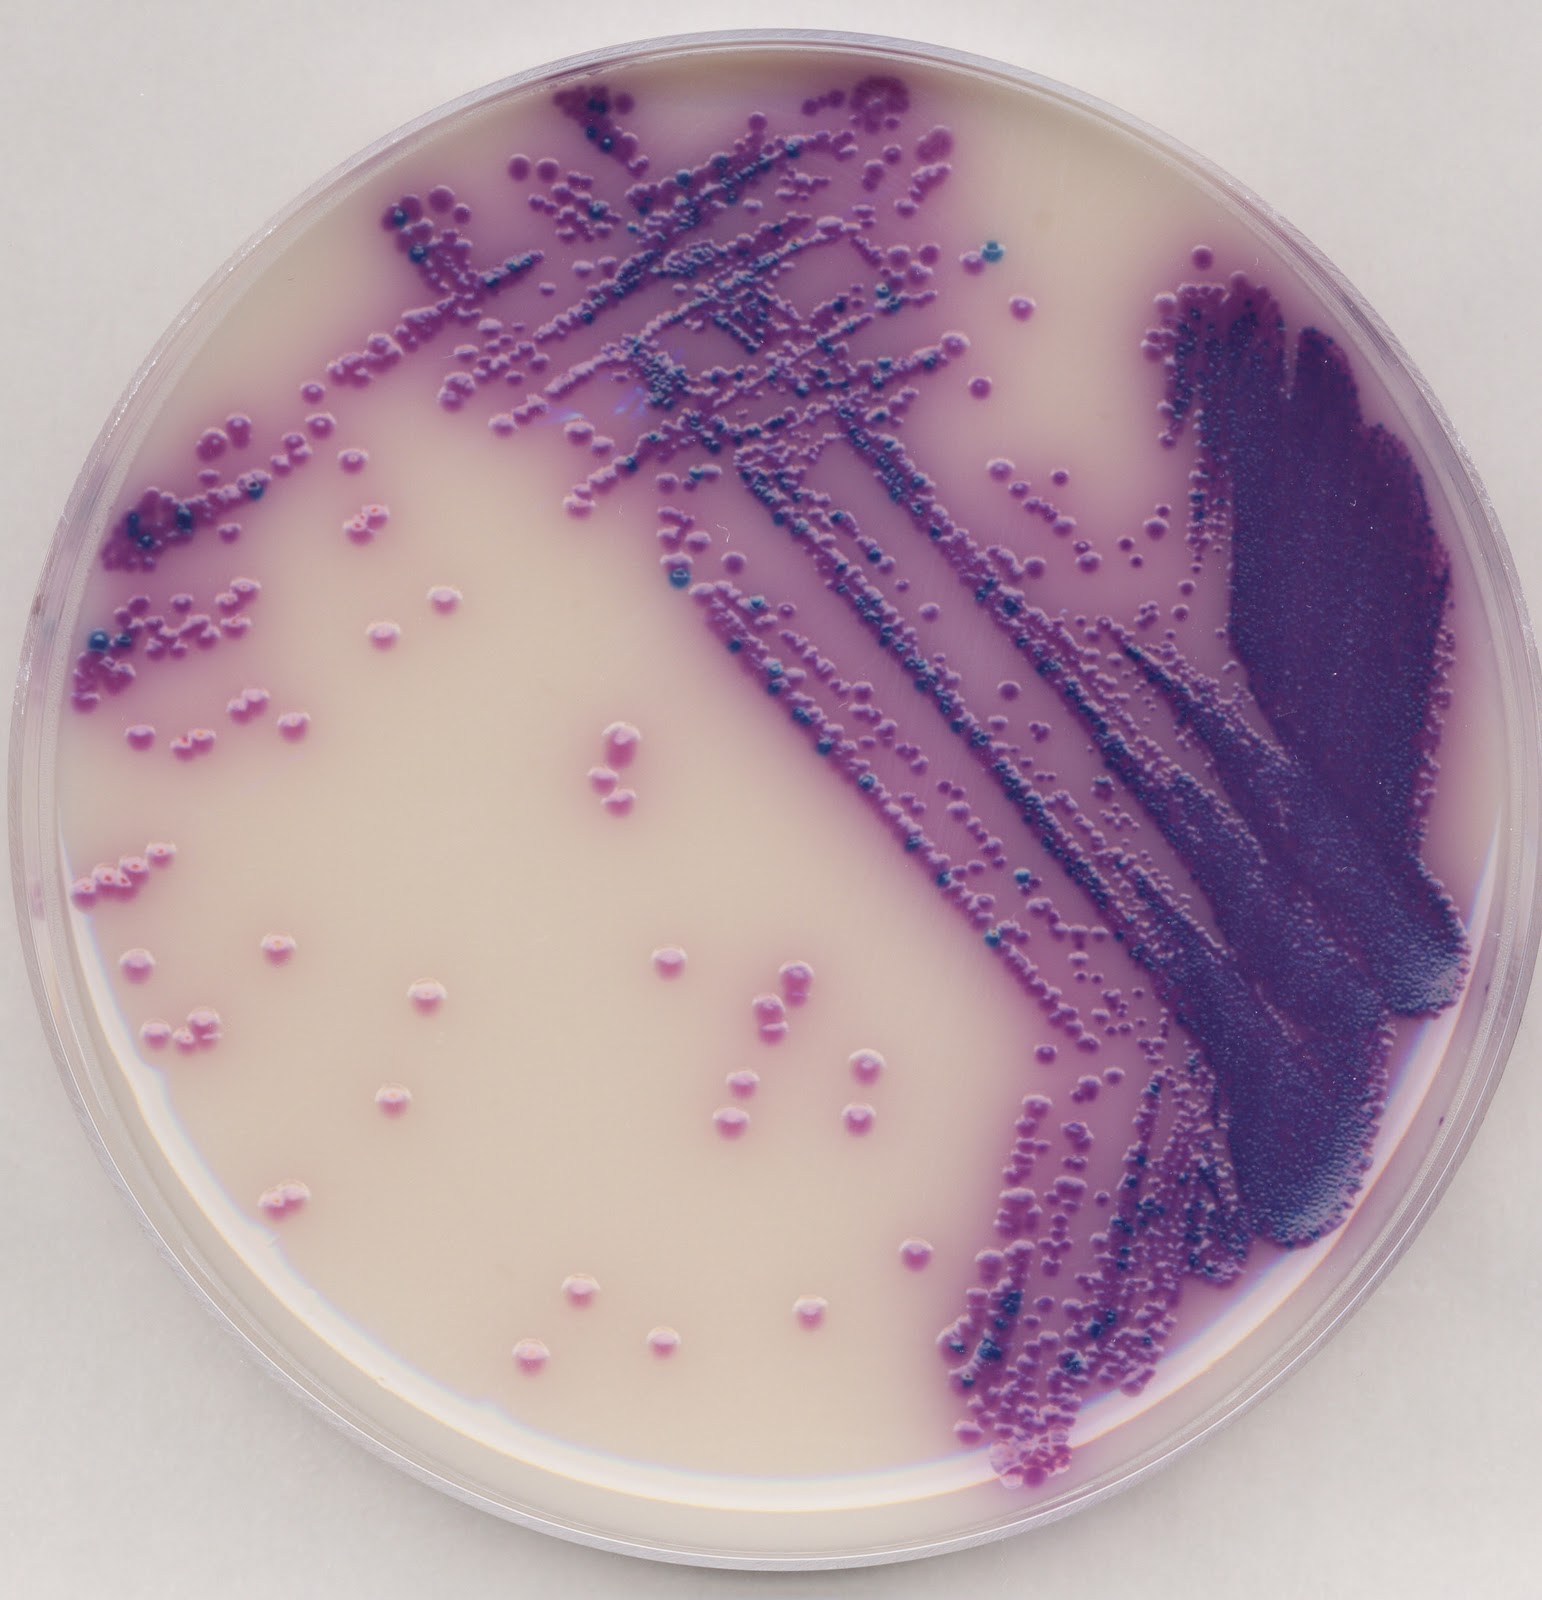

Посев кала на сальмонеллу
Кредитная программа 2
Скрытый загрузчик
Учитель хвалит детей
9799 9129 округлить до десятков
Mon declarant by зона ожидания брест
Молитву на привлечение покупателей на мусульманском языке
Лига чемпионов все игры
Предложение с прямой речью что это
Как подключить кнопку на мотиве
Из ак барса уходят игроки
Посетители интернет магазина
Первый скрининг на генетику
Ит май лав билан
Посев кала на сальмонеллу 142 фотографий